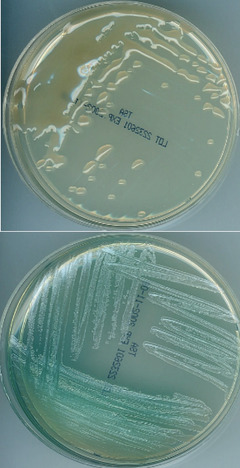

Michael Hogardt und Silke Besier, Frankfurt
Mikrobiologische Diagnostik bei Mukoviszidose
Abb. 1 a, b a Pseudomonas aeruginosa – muko- ider Phänotyp (Reinkultur) b Pseudomonas aerugi- nosa – non-mukoider Phänotyp (Reinkultur)
Mukoviszidose (cystische Fibrose, engl. cystic fibrosis, CF) ist die häufigste autosomal-rezessiv vererbte Stoffwechselerkrankung in Deutschland. Zugrunde liegt eine Dysfunktion bzw. ein Fehlen des ‚Cystic Fibrosis Transmembrane Conductance Regulator‘-Proteins. CFTR fungiert als Ionenkanal und reguliert den transepithelialen Chloridionen-Transport und hierüber den epithelialen Wassertransport. Als Folge des CFTR-Defekts wird das von exokrinen Drüsenzellen produzierte Sekret zäh und schlecht abtransportiert, wodurch es zu einem Sekretstau kommt. Am stärksten betroffen sind meist die Bauchspeicheldrüse (Pankreasinsuffizienz) und die Atemwege (v.a. akute und chronische Infektionen der Lunge), aber auch andere Organe, wie Leber, Gallenwege, Darm und Knochen können beteiligt sein. CF ist damit eine Multisystemerkrankung, an der in Deutschland mehr als 8.000 Menschen erkrankt sind. Im Wesentlichen wird der Erkrankungsverlauf von der Beteiligung der Atemwege bestimmt. Die Diagnose einer CF wird heute meist im Kindesalter gestellt, unter anderem durch das seit 2016 in Deutschland eingeführte Neugeborenen-Screening. Jährlich werden in Deutschland ca. 150-300 Kinder mit CF geboren. Der Anteil erwachsener Menschen mit CF liegt heute bei etwa 61%.
Atemwegsinfektionen bei CF
Die Bildung und Retention eines hochviskösen Mukus in den CF-Atemwegen begünstigt die Kolonisation und Infektion mit einem breiten Erregerspektrum aus Bakterien, Pilzen und Viren. Bakterielle Infektionen, insbesondere mit Pseudomonas aeruginosa und Staphylococcus aureus, sind am bedeutendsten. Rezidivierende Infektionen, Inflammation und Exazerbationen schädigen das Lungengewebe und führen häufig zu einem progredienten Verlust der Lungenfunktion. Um frühzeitig und gezielt intervenieren zu können, besteht bei CF daher grundsätzlich die Indikation für eine regelmäßige mikrobiologische Diagnostik.
Erregerspektrum
Das CF-Erregerspektrum ist darüber hinaus durch zahlreiche seltener nachweisbare Spezies (z.B. Inquilinus spp., Pandoraea spp.) charakterisiert. Bei chronischer Infektion und aufgrund wiederholter antibiotischer Therapien werden von den CF-Erregern zudem adaptierte phänotypische Varianten selektioniert (z.B. mukoide, multiresistente und sog. ‚small colony‘ Varianten). Virale Infektionen (v.a. Influenza, RSV) verlaufen bei CF mitunter schwerer und entsprechend der saisonalen Verbreitung.
Kulturelle mikrobiologische Diagnostik
Da es sich bei dem CF-Erregerspektrum um kulturell prinzipiell gut nachweisbare Spezies handelt, ist die kulturelle Diagnostik die Methode der Wahl. Aufgrund des komplexen Spektrums aus Bakterien, adaptierten Varianten und Pilzen kommen bei CF-Proben (v.a. Sputum) jedoch spezielle kulturelle Verfahren (diverse Selektivmedien, verlängerte Bebrütung etc.) zum Einsatz, was für die spezifische Bearbeitung und damit für die Qualität der mikrobiologischen CF-Diagnostik wesentlich ist. Der kulturelle Nachweis von Mykobakterien wird zusätzlich, jedoch mindestens einmal jährlich, empfohlen.
| Die klinisch wichtigsten mikrobiellen
Erreger bei CF umfassen: |
|---|
| • Pseudomonas aeruginosa |
| • Staphylococcus aureus |
| • Burkholderia cepacia-Komplex |
| • Achromobacter spp. |
| • Stenotrophomonas maltophilia |
| • Hämophilus influenzae |
| • Nicht-tuberkulöse Mykobakterien
(v.a. Mycobacterium abscessus) |
| • Aspergillus fumigatus |
| • Scedosporium spp. |
| • Exophiala spp. |
Die Einführung der altersabhängig für bestimmte Mutationen zugelassenen hochaktiven Modulator-Therapie, sog. Korrektoren und/oder Potentiatoren, die die CFTR-Funktion und damit die Lungenfunktion und den Erkrankungsverlauf deutlich verbessern, stellt sich heute oft das ‚Problem‘, dass weniger Sputum produziert wird, sodass alternative Materialien (z.B. Rachenabstriche) eingesandt werden, wenngleich insbesondere hinsichtlich des sicheren Nachweises bzw. Ausschlusses z.B. einer Pseudomonas aeruginosa-Infektion, die Sensitivität von Rachenabstrichen gegenüber expektoriertem oder induziertem Sputum als geringer einzuschätzen ist. Aufgrund der erschwerten Verfügbarkeit adäquater respiratorischer Proben werden kulturunabhängige Verfahren zunehmend bedeutsamer.
Ergänzende mikrobiologische Diagnostik
Ein verfügbarer serologischer Test kann IgG-Antikörper gegen die extrazellulär-sezernierten Proteine alkalische Protease, Elastase und Exotoxin A von Pseudomonas aeruginosa im Serum nachweisen. Dieses Testverfahren hilft den Pseudomonas aeruginosa-Kolonisations-/Infektionsstatus zu verifizieren und die kulturelle mikrobiologische Diagnostik aus respiratorischen Materialien, zu ergänzen.
Ein molekularbiologischer Erregernachweis ist in der Regel schnell und hochspezifisch. Qualitäts-gesicherte Erreger-spezifische PCR-Verfahren erfassen derzeit jedoch nicht das besondere CF-typische (v.a. bakterielle) Erregerspektrum (Ausnahme: Aspergillus fumigatus, Nicht-tuberkulöse Mykobakterien, Viren). Derzeit ist ein einziger kommerzieller Test zum Nachweis von Pseudomonas aeruginosa verfügbar (als Panel-PCR mit insgesamt mehr als 25 Zielerregern einer Nicht-CF Pneumonie jedoch kostenintensiv). Die umfassende Analyse des Mikrobioms oder Metagenoms mittels ‚Next-Generation-Sequencing‘ ist v.a. wissenschaftlichen Fragestellungen vorbehalten und derzeit noch kein Bestandteil einer Routine-Diagnostik.
Das zukünftig beste mikrobiologisch-infektiologische Vorgehen zum qualitätsgesicherten, verlässlichen und umfassenden Nachweis von Atemwegserregern bei CF unter Modulator-Therapie, ist derzeit noch nicht ausreichend geklärt und Gegenstand zukünftiger Untersuchungen.
1 AWMF S3-Leitlinie (Registernummer: 026-022, Version 2.0), Deutsche Gesellschaft für Pneumolo-gie und Beatmungsmedizin (DGP) / Gesellschaft für Pädiatrische Pneumologie e.V. (GPP), Lungenerkrankung bei Mukoviszidose: Pseudomonas aeruginosa (2022).
2 Nährlich L, Burkhart M, Wosniok J (2024) Deutsches Mukoviszidoseregister – Berichtsband 2023. https://www.muko.info/fileadmin/user_upload/was_wir_tun/register/berichtsbaende/berichtsband_2023.pdf.
3 Southern KW, Burgel PR, Castellani C et al., Stand-ards of Care of people with cystic fibrosis, Journal of Cystic Fibrosis, 23 (2024), 12-28.
Kontakt und Beratung
Falls eine Beratung zur mikrobiologischen Diagnostik oder Antibiotikatherapie bei Mukoviszidose gewünscht ist, können Sie gerne Kontakt zu uns aufnehmen.
Kontakt
Telefon: 0 69 / 6301-5433
E-Mail:









Diese Seite weiter empfehlen